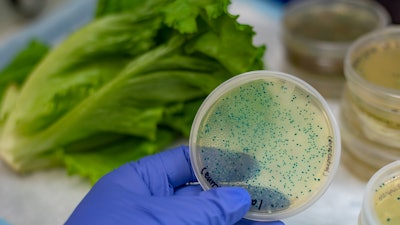

The U.S. Food and Drug Administration, along with the U.S. Centers for Disease Control and Prevention and state and local partners, previously reported on Dec. 12 that public health experts were tracking three separate outbreaks linked to romaine lettuce caused by three different strains of E. coli O157:H7. We also reported that, through the FDA’s traceback investigation, we were able to identify a common grower between each of these outbreaks in Salinas, CA based on available supply chain information.
Today, the FDA is providing an update on the status of the E. coli O157:H7 illnesses linked to romaine lettuce, along with recent findings based on our investigation of fields linked to a common grower, which was identified in our traceback. It should be noted that romaine from this grower does not explain all of the illnesses seen in these outbreaks.
Outbreaks declared over, consumer advisory lifted
The FDA is lifting the consumer advisory to avoid romaine lettuce from Salinas as the growing season for this region is over, and there is no longer a need for consumers to avoid it. There is also no need to avoid other produce products from Salinas.
The FDA and CDC have been tracking two multi-state romaine lettuce outbreaks. As of Jan. 15, federal health officials are declaring both multi-state romaine lettuce outbreaks over. One of the outbreaks sickened 167 people in 27 states. The other outbreak, linked to Fresh Express salad kits, sickened 10 people in five states.
There was also a third outbreak in Washington State that sickened 11 people. This outbreak has also been declared over.
The last reported illness onset date for all the outbreaks was Dec. 21. Based on this information, it appears that our Nov. 22 advisory to not eat romaine from Salinas played an important role in preventing illnesses and containing this outbreak because it prompted the removal of romaine lettuce from Salinas from the marketplace and warned consumers to throw away romaine from that growing region.
Common grower, multiple fields investigated
The FDA traceback investigation for these outbreaks required investigators to go through hundreds of supply chain records to find a commonality to a single grower with multiple fields. We were able to narrow this down further to at least 10 fields in the lower Salinas Valley.
Investigators from the FDA, CDC, the California Department of Food and Agriculture and the California Department of Public Health, visited several of these fields and took a variety of samples from water, soil and compost. So far, sample results have come back negative for all of the three outbreak strains of E. coli O157:H7. However, we did find a strain of E. coli that is unrelated to any illnesses in a soil sample taken near a run-off point in a buffer zone between a field where product was harvested and where cattle are known to occasionally graze. This could be an important clue that will be further examined as our investigation continues. However, this clue does not explain the illnesses seen in these outbreaks.
Our investigation is ongoing, and we are doing everything possible to find the source or sources of contamination. The investigation into how this contamination occurred is important, so romaine growers can implement measures that will prevent future contamination and illnesses.
The FDA is planning to conduct an additional, in-depth, root-cause investigation. The investigation will further characterize how contamination might have occurred and will inform what preventive controls are needed to prevent future outbreaks. Once complete, we plan to issue a prompt report and share lessons learned, so that growers can implement best practices to protect consumers from contaminated produce.
Investigation will inform future prevention
As we mentioned in our last update, it is important to remember that millions of servings of fresh leafy greens are safely eaten every day by consumers, although the repeat nature of these outbreaks linked to leafy greens – and more specifically to romaine lettuce – remains a concern.
We are doing our part by continuing our sampling assignment to monitor for pathogens in romaine lettuce across the nation. Industry can and must do their part too. Everyone across the romaine supply chain must do everything possible to fully understand why and how these outbreaks keep happening and continue to aggressively implement preventive measures to further protect consumers.






















